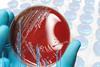
Bruker feature image

Webinars
-
 Webinar
WebinarThe either-or trap: consequences of enhanced mechanical calibration vs fully qualifying your dissolution equipment
Register for this exclusive USP webinar
-
 Webinar
WebinarHow thermal analysis can enhance pharmaceutical drug development
This webinar will discuss three core techniques to optimise drug development through assessment of a material’s stability, composition, impurities, humidity effects, and thermal properties.
-
 Webinar
WebinarPractical steps for innovating pharmaceutical manufacturing
During this virtual panel, industry experts will discuss practical examples and considerations for transforming manufacturing processes.
-
 Webinar
WebinarOptimising efficiency and yield through bioprocessing automation
Join this webinar to explore how process Raman spectroscopy can support bioprocessing automation across upstream and downstream workflows.
-
 Webinar
WebinarSmarter Raman QC for biopharma fill-finish with scalable model transfer
Join this webinar to explore how modern Raman spectroscopy is transforming biopharma fill-finish quality control through faster analysis, multi-attribute insight, and scalable model transfer.
-
 Webinar
WebinarHarnessing digital PCR for rapid sterility testing
Explore rapid sterility testing methods that ensure fast, reliable product release, addressing critical challenges in timely delivery and safety.
-
 Webinar
WebinarHarnessing AI for more efficient clinical trials
During this virtual panel, industry experts discussed practical examples and considerations for applying AI in pharma’s clinical trials.
-
 Webinar
WebinarPractical considerations for aseptic gowning in contamination control strategies
Watch this webinar as we examine the main personnel-related factors that could lead to particle/microbial contamination risks of the product and outline practical measures that can mitigate these risks.
-
 Webinar
WebinarComplying with USP Chapters 41 and 1251 revisions for pharma quality control
Join this webinar to gain insight about the changes to United States Pharmacopeia (USP) General Chapters 41 and 1251 on balance requirements for quality control.
-
 Webinar
WebinarIncreasing the effectiveness of pharma endotoxin testing
During this virtual panel, industry experts will discuss the evolution of endotoxin testing, future trends and key risk mitigation considerations for pharma companies.
-

-
 Webinar
WebinarAutomating quality control testing for radiopharmaceutical production
This webinar showcased a rapid microbial method that can help to address the time to result challenge posed by short shelf-life radiopharmaceuticals.
-
 Webinar
WebinarThe future of sterility testing: one-day results with advanced RT-rt PCR technology
Watch this webinar to find out how RT-rt PCR is revolutionising sterility testing and discover a unique approach that provides reliable one-day results and enhanced sensitivity and detection capabilities.
-
 Webinar
WebinarMastering impurity profiling: USP’s evolving standards and strategies
Watch our webinar with USP as they explored new approaches for impurity profiling - unveiling new frameworks, analytical tools, and regulatory insights that are reshaping pharmaceutical quality standards.
-
Webinar
WebinarThe future of contamination control in pharma: from compliance to innovation
This webinar explores the benefits of accelerated microbial identification using MALDI-TOF in pharmaceutical contamination control strategies.
-
 Webinar
WebinarBest practices for PUPSIT assembly design and operation
This webinar explores the design and implementation of pre use post sterilisation integrity test assemblies (PUPSIT) in sterile filtration processes to ensure regulatory compliance while minimising operational risk.
-
 Webinar
WebinarHarnessing AI to transform quality and manufacturing in life sciences
This webinar explores innovative, purpose-built AI solutions that elevate compliance and efficiency in quality and manufacturing operations.
-
 Webinar
WebinarLipid formulations in softgels - enhancing bioavailability and therapeutic efficacy
This webinar will explore how lipid formulations in softgels can enhance drug absorption and bioavailability.
-
 Webinar
WebinarRisks in pharmaceutical quality - the role of reference standards in analytical procedures
Join this webinar to learn about the essential role of Reference Standards in mitigating risks to pharmaceutical quality.
-
 Webinar
WebinarControlling impurities in pharmaceutical waters
This virtual panel explores impurity control in pharmaceutical waters, the differences between microbial and organic contaminants, and best practices for measurement and treatment.



